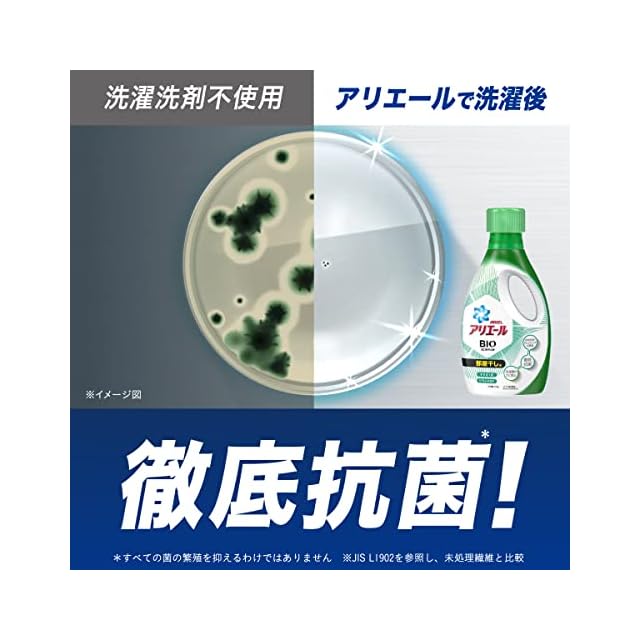

1/8
アリエール バイオサイエンス 部屋干し 洗濯洗剤 液体 抗菌&菌のエサまで除去 詰め替え 1000g
¥2,167 税込
SOLD OUT
この商品は送料無料です。
【送料無料】
【商品概要】
科学と自然の力で大改良アリエールバイオサイエンス。科学の洗浄力と自然の分解力で洗浄力の限界突破*。落ちにくいえりソデ汚れもしっかり落とします。*P&G従来品比較
独自の抗菌成分配合で干している間、着用中も徹底抗菌* *すべての菌の増殖を抑えるわけではありません。
洗濯槽クリーナーなしでも洗濯槽のカビ対策OK! 洗濯槽の防カビもできます。
レノアxファブリーズ共同開発。部屋干し時のタオルのニオイ癖までしっかりクレンジング&消臭します。
液だれ防止キャップなので、あの嫌な液だれもしっかり防ぎます。
【商品説明】
【商品詳細】
-
送料・配送方法について
-
お支払い方法について
¥2,167 税込
SOLD OUT
最近チェックした商品
同じカテゴリの商品
その他の商品